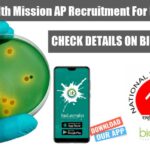
National Health Mission AP Recruitment – Applications Invited National Health Mission AP

Home Search
microbiology - search results
If you're not happy with the results, please do another search
Sathyabama Institute of Science and Technology Project Associate Jobs
Sathyabama Project Associate Jobs - MSc Biotech, Life Sciences Apply
Sathyabama Project Associate Jobs - MSc Biotech, Life Sciences Apply. Sathyabama Institute of Science and...
IFF Dairy Application Specialist Job For Food Science Technology
IFF Dairy Application Specialist Job For Food Science Technology
IFF Dairy Application Specialist Job For Food Science Technology. Food science technology dairy application specialist jobs....
ACTREC Research Coordinator Job With Rs. 91,000 pm Pay For MSc & PhD Life...
ACTREC Research Coordinator Job With Rs. 91,000 pm Pay
ACTREC Research Coordinator Job With Rs. 91,000 pm Pay. MSc & PhD Biotech, Zoology, Life Science,...
ICMR Funded JRF Position Vacant at Sankara Nethralaya, Medical Research Foundation, Chennai
Medical Research Foundation Job - Life Sciences JRF Vacancy
Applications are invited for one position of Junior Research Fellow (JRF) in a research project funded...
AIIMS Delhi Senior Research Officer Recruitment For MSc & PhD
Research Officer AIIMS Job - MSc & PhD Life Sciences Apply
Research Officer AIIMS Job - MSc & PhD Life Sciences Apply. AIIMS New Delhi...
Biotecnika Times Newsletter 29.11.2021 NABI Research Training, National Cancer Tissue
Biotecnika Times - NABI Research Training, National Cancer Tissue
4-6 Months Research Training With Project Opportunity at NABI - Apply On Biotecnika App
NABI, Mohali has...
Development of Assay for SARS-CoV-2 Project at University of Calcutta
Calcutta University SRF Vacancy For Life Sciences, Applications Invited
Calcutta University SRF Vacancy For Life Sciences, Applications Invited. MSc Life Sciences Senior Research Fellow Jobs....
ICAR Millets Research Project Recruitment With Rs. 1 Lakh pm Pay
ICAR Millets Research Project Recruitment With Rs. 1 Lakh pm Pay
ICAR Millets Research Project Recruitment With Rs. 1 Lakh pm Pay. ICAR –
Indian Institute...
Biotecnika Times Newsletter 25.11.2021 Indian Pharmacopoeia Commission Hiring, BTech
Biotecnika Times- Indian Pharmacopoeia Commission Hiring, BTech
Indian Pharmacopoeia Commission (IPC) Recruitment - Download Biotecnika App to Apply
Indian Pharmacopoeia Commission Jobs For Biotech & Biochem....
Institute of Pesticide Formulation Technology Recruitment For BTech, MSc & PhD
IPFT Jobs - Biotechnology, Microbiology & Biological Sciences Apply
IPFT Jobs - Biotechnology, Microbiology & Biological Sciences Apply. BTech, MSc & PhD Biochemistry/ Biotechnology/ Biological...
National Health Mission AP Recruitment – Applications Invited
National Health Mission AP Recruitment - Applications Invited
National Health Mission AP Recruitment - Applications Invited. Applied Microbiology / General Microbiology/ Biotechnology / Biochemistry, BSc...
ACTREC Project Scientific Assistant Recruitment For Biological & Life Sciences
ACTREC Project Scientific Assistant Recruitment For Biological & Life Sciences
ACTREC Project Scientific Assistant Recruitment For Biological & Life Sciences. BSc Microbiology / Biotechnology /...
NIAB Project Jobs With Rs. 42,000 pm Pay – MSc, MTech & PhD Life...
NIAB Project Jobs For Life Sciences, MSc/ MTech & PhD Apply
NIAB Project Jobs For Life Sciences, MSc/ MTech & PhD Apply. M. Tech. MSc...
Biotecnika Times Newsletter 23.11.2021 CSIR-NCL Recruitment, inStem Life Science Job
Biotecnika Times - CSIR-NCL Recruitment, inStem Life Science Job
inStem Life Sciences Project Scientist Recruitment - Download Biotecnika App to Apply
inStem Life Sciences Project Scientist...
JIPMER Life Sciences Job With Rs. 67,000 pm Pay, Applications Invited
JIPMER Life Sciences Job With Rs.67,000 pm Pay, Applications Invited
JIPMER Life Sciences Job With Rs.67,000 pm Pay, Applications Invited. Scientist C Vacancy at JIPMER....